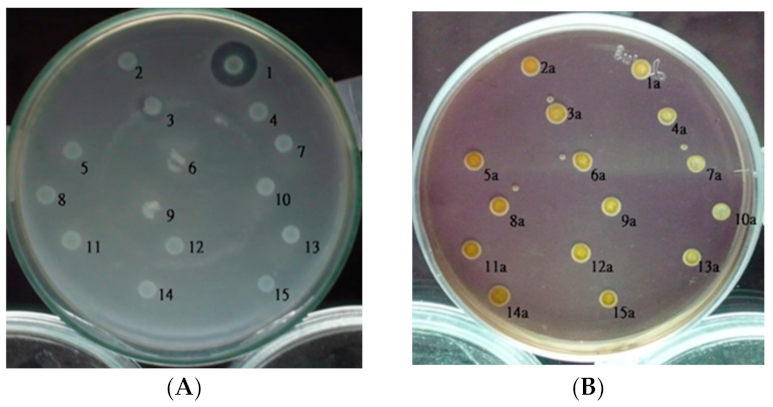
Ijms 23 05649 g001 Ijms 23 05649 g001
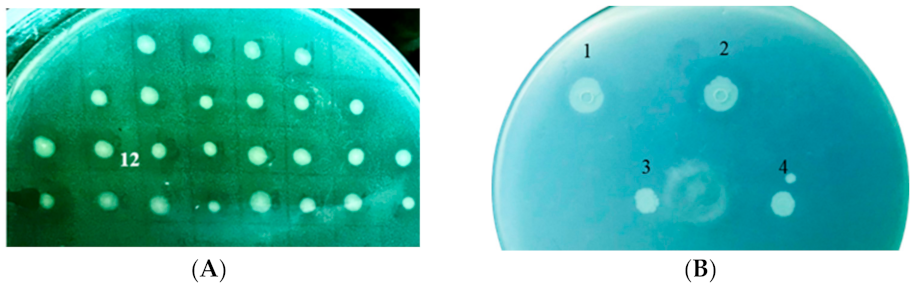
Ijms 23 05649 g002 Ijms 23 05649 g002

Diguanylate Cyclase (DGC) Implicated in the Synthesis of Multiple Bacteriocins via the Flagellar-Type III Secretion System Produced by Pectobacterium carotovorum subsp. carotovorum
Abstract
1. Introduction
2. Results
2.1. Isolation and Detection of Tn5 Insertion Mutants
2.2. DNA Amplification at the Tn5 Insertion Junction
2.3. Role of DGC on Pcc’s Bacteriocin Secretion
2.4. Regulation of DGC on Pcc’s Bacteriocin Secretion
2.5. Extracellular L-Glutamine Concentrations Have Varied Effects on 89-H-rif-12
3. Discussion
4. Materials and Methods
5. Conclusions
Supplementary Materials
Author Contributions
Funding
Institutional Review Board Statement
Informed Consent Statement
Data Availability Statement
Conflicts of Interest
References
- Tischler, A.D.; Camilli, A. Cyclic Diguanylate (C-Di-GMP) Regulates Vibrio Cholerae Biofilm Formation. Mol. Microbiol. 2004, 53, 857–869. [Google Scholar] [CrossRef] [PubMed]
- Zogaj, X.; Nimtz, M.; Rohde, M.; Bokranz, W.; Romling, U. The Multicellular Morphotypes of Salmonella Typhimurium and Escherichia coli Produce Cellulose As The Second Component of The Extracellular Matrix. Mol. Microbiol. 2001, 39, 1452–1463. [Google Scholar] [CrossRef] [PubMed]
- Aldridge, P.; Paul, R.; Goymer, P.; Rainey, P.; Jenal, U. Role of The GGDEF Regulator Pled In Polar Development of Caulobacter Crescentus. Mol. Microbiol. 2003, 47, 1695–1708. [Google Scholar] [CrossRef] [PubMed]
- Jenal, U.; Reinders, A.; Lori, C. Cyclic Di-GMP: Second Messenger Extraordinaire. Nat. Rev. Genet. 2017, 15, 271–284. [Google Scholar] [CrossRef]
- Chan, C.; Paul, R.; Samoray, D.; Amiot, N.C.; Giese, B.; Jenal, U.; Schirmer, T. Structural Basis of Activity and Allosteric Control Of Diguanylate Cyclase. Proc. Natl. Acad. Sci. USA 2004, 101, 17084–17089. [Google Scholar] [CrossRef]
- Teixeira, R.D.; Holzschuh, F.; Schirmer, T. Activation mechanism of a small prototypic Rec-GGDEF diguanylate cyclase. Nat. Commun. 2021, 12, 2162. [Google Scholar] [CrossRef]
- Römling, U.; Gomelsky, M.; Galperin, M. C-Di-GMP: The Dawning of A Novel Bacterial Signalling System. Mol. Microbiol. 2005, 57, 629–639. [Google Scholar] [CrossRef]
- Jenal, U. Cyclic Di-Guanosine-Monophosphate Comes of Age: A Novel Secondary Messenger Involved in Modulating Cell Surface Structures in Bacteria? Curr. Opin. Microbiol. 2004, 7, 185–191. [Google Scholar] [CrossRef]
- D’Argenio, D.A.; Miller, S.I. Cyclic Di-GMP as A Bacterial Second Messenger. Microbiology 2004, 150, 2497–2502. [Google Scholar] [CrossRef]
- Sudarsan, N.; Lee, E.R.; Weinberg, Z.; Moy, R.H.; Kim, J.N.; Link, K.H.; Breaker, R.R. Riboswitches in Eubacteria Sense The Second Messenger Cyclic Di-GMP. Science 2008, 321, 411–413. [Google Scholar] [CrossRef]
- Nelson, J.; Sudarsan, N.; Furukawa, K.; Weinberg, Z.; Wang, J.X.; Breaker, R.R. Riboswitches in Eubacteria Sense The Second Messenger C-Di-AMP. Nat. Chem. Biol. 2013, 9, 834–839. [Google Scholar] [CrossRef] [PubMed]
- Fazli, M.; O’Connell, A.; Nilsson, M.; Niehaus, K.; Dow, J.M.; Givskov, M.; Ryan, R.P.; Tolker-Nielsen, T. The CRP/FNR Family Protein Bcam1349 Is A C-Di-GMP Effector That Regulates Biofilm Formation in The Respiratory Pathogen Burkholderia Cenocepacia. Mol. Microbiol. 2011, 82, 327–341. [Google Scholar] [CrossRef] [PubMed]
- Chin, K.-H.; Lee, Y.-C.; Tu, Z.-L.; Chen, C.-H.; Tseng, Y.-H.; Yang, J.-M.; Ryan, R.P.; McCarthy, Y.; Dow, J.M.; Wang, A.H.-J.; et al. The Camp Receptor-Like Protein CLP Is A Novel C-Di-GMP Receptor Linking Cell–Cell Signaling to Virulence Gene Expression in Xanthomonas Campestris. J. Mol. Biol. 2010, 396, 646–662. [Google Scholar] [CrossRef] [PubMed]
- McCarthy, R.R.; Valentini, M.; Filloux, A. Contribution of Cyclic Di-GMP in The Control of Type III and Type VI Secretion in Pseudomonas aeruginosa. C-Di-GMP Signaling; Humana Press: New York, NY, USA, 2017; pp. 213–224. [Google Scholar] [CrossRef]
- Trampari, E.; Stevenson, C.E.M.; Little, R.H.; Wilhelm, T.; Lawson, D.M.; Malone, J.G. Bacterial Rotary Export Atpases Are Allosterically Regulated By The Nucleotide Second Messenger Cyclic-Di-GMP. J. Biol. Chem. 2015, 290, 24470–24483. [Google Scholar] [CrossRef]
- Haque, M.M.; Oliver, M.H.; Nahar, K.; Alam, M.Z.; Hirata, H.; Tsuyumu, S. Cytr Homolog of Pectobacterium Carotovorum Subsp. Carotovorum Controls Air-Liquid Biofilm Formation By Regulating Multiple Genes involved in Cellulose Production, C-Di-GMP Signaling, Motility, and Type III Secretion System in Response to Nutritional and Environmental Signals. Front. Microbiol. 2017, 8, 972. [Google Scholar] [CrossRef]
- Tseng, T.-T.; Tyler, B.M.; Setubal, J.C. Protein Secretion Systems in Bacterial-Host associations, and Their Description in The Gene Ontology. BMC Microbiol. 2009, 9, S2. [Google Scholar] [CrossRef]
- Baena, F.J.L.; Vinardell, J.-M.; Medina, C. Regulation of Protein Secretion Systems Mediated By Cyclic Diguanylate in Plant-interacting Bacteria. Front. Microbiol. 2019, 10, 1289. [Google Scholar] [CrossRef]
- Wu, H.-P.; Derilo, R.C.; Chen, H.-L.; Li, T.-R.; Lagitnay, R.B.J.S.; Chan, Y.-C.; Chuang, Y.; Chuang, D.-Y. Injectisome T3SS Subunits as Potential Chaperones in The Extracellular Export of Pectobacterium Carotovorum Subsp. Carotovorum Bacteriocins Carocin S1 and Carocin S3 Secreted Via Flagellar T3SS. BMC Microbiol. 2021, 21, 345. [Google Scholar] [CrossRef]
- Hengge, R. Principles of c-di-GMP signalling in bacteria. Nat. Rev. Microbiol. 2009, 7, 263–273. [Google Scholar] [CrossRef]
- Bolivar, F.; Rodriguez, R.L.; Greene, P.J.; Betlach, M.C.; Heyneker, H.L.; Boyer, H.W.; Crosa, J.H.; Falkow, S. Construction and Characterization of New Cloning Vehicle. II. A Multipurpose Cloning System. Gene 1977, 2, 95–113. [Google Scholar] [CrossRef]
- Hockett, K.L.; Baltrus, D.A. Use of the soft-agar overlay technique to screen for bacterially produced inhibitory compounds. J. Vis. Exp. 2017, 119, 55064. [Google Scholar] [CrossRef] [PubMed]
- Gause, W.C.; Adamovicz, J. The Use of The PCR to Quantitate Gene Expression. Genome Res. 1994, 3, S123–S135. [Google Scholar] [CrossRef]
- Tang, Y.W. Advanced Techniques in Diagnostic Microbiology; Springer: New York, NY, USA, 2012; ISBN 978-1461439691. [Google Scholar]
- Chan, Y.-C.; Wu, H.-P.; Chuang, D.-Y. Extracellular Secretion of Carocin S1 in Pectobacterium Carotovorum Subsp. Carotovorumoccurs Via The Type III Secretion System integral to The Bacterial Flagellum. BMC Microbiol. 2009, 9, 181. [Google Scholar] [CrossRef] [PubMed]
- Lee, M.-C.; Weng, S.-F.; Tseng, Y.-H. Flagellin Gene Flic of Xanthomonas Campestris Is Upregulated By Transcription Factor Clp. Biochem. Biophys. Res. Commun. 2003, 307, 647–652. [Google Scholar] [CrossRef]
- A Lloyd, S.; Tang, H.; Wang, X.; Billings, S.; Blair, D.F. Torque Generation in The Flagellar Motor of Escherichia coli: Evidence of a Direct Role for Flig But Not for Flim or Flin. J. Bacteriol. 1996, 178, 223–231. [Google Scholar] [CrossRef] [PubMed]
- Paul, K.; Nieto, V.; Carlquist, W.C.; Blair, D.F.; Harshey, R.M. The C-Di-GMP Binding Protein Ycgr Controls Flagellar Motor Direction and Speed to Affect Chemotaxis By A “Backstop Brake” Mechanism. Mol. Cell 2010, 38, 128–139. [Google Scholar] [CrossRef] [PubMed]
- Fang, X.; Gomelsky, M. A Post-Translational, C-Di-GMP-Dependent Mechanism Regulating Flagellar Motility. Mol. Microbiol. 2010, 76, 1295–1305. [Google Scholar] [CrossRef]
- Ryjenkov, D.A.; Simm, R.; Römling, U.; Gomelsky, M. The Pilz Domain Is A Receptor For The Second Messenger C-Di-GMP. J. Biol. Chem. 2006, 281, 30310–30314. [Google Scholar] [CrossRef]
- Planche, T. Plasma Glutamine and Glutamate Concentrations in Gabonese Children With Plasmodium Falciparum infection. QJM 2002, 95, 89–97. [Google Scholar] [CrossRef][Green Version]
- Tullius, M.V.; Harth, G.N.; Horwitz, M.A. Glutamine synthetase GlnA1 is essential for growth of Mycobacterium tuberculosis in human THP-1 macrophages and guinea pigs. Infect. Immun. 2003, 71, 3927–3936. [Google Scholar] [CrossRef]
- Hanahan, D. Studies On Transformation of Escherichia coli with Plasmids. J. Mol. Biol. 1983, 166, 557–580. [Google Scholar] [CrossRef]
- Haber, A.; Friedman, S.; Lobel, L.; Burg-Golani, T.; Sigal, N.; Rose, J.; Livnat-Levanon, N.; Lewinson, O.; Herskovits, A.A. L-Glutamine induces Expression of Listeria Monocytogenes Virulence Genes. PLOS Pathog. 2017, 13, e1006161. [Google Scholar] [CrossRef] [PubMed]
- Minato, Y.; Fassio, S.R.; Wolfe, A.J.; Häse, C.C. Central Metabolism Controls Transcription of A Virulence Gene Regulator in Vibrio Cholerae. Microbiology 2013, 159, 792–802. [Google Scholar] [CrossRef] [PubMed]
- Reusch, R.N.; Hiske, T.W.; Sadoff, H.L. Poly-Beta-Hydroxybutyrate Membrane Structure and Its Relationship to Genetic Transformability in Escherichia coli. J. Bacteriol. 1986, 168, 553–562. [Google Scholar] [CrossRef]
- Gantotti, B.V.; Kindle, K.L.; Beer, S.V. Transfer of the drug-resistance transposon Tn5 to Erwinia herbicola and the induction of insertion mutations. Curr. Microbiol. 1981, 6, 377–381. [Google Scholar] [CrossRef]
- Hirsch, P.; Beringer, J. A Physical Map of Pph1ji and Pjb4ji. Plasmid 1984, 12, 139–141. [Google Scholar] [CrossRef]
- Sambrook, J.; Russel, D.W. Molecular Cloning: A laboratory Manual, 3rd ed.; Cold Spring Harbor Laboratory Press: New York, NY, USA, 2001. [Google Scholar]
- Liu, H.; Naismith, J.H. An Efficient One-Step Site-Directed Deletion, insertion, Single and Multiple-Site Plasmid Mutagenesis Protocol. BMC Biotechnol. 2008, 8, 91. [Google Scholar] [CrossRef]
- Addgene: Handling Plasmids from Addgene—Purifying Plasmid DNA. Addgene.org. Available online: https://www.addgene.org/protocols/purify-plasmid-dna/ (accessed on 15 March 2021).
- Liu, Y.-G.; Whittier, R.F. Thermal asymmetric interlaced PCR: Automatable Amplification and Sequencing of insert End Fragments From P1 and YAC Clones For Chromosome Walking. Genomics 1995, 25, 674–681. [Google Scholar] [CrossRef]
- Chiu, J. Site-Directed, Ligase-independent Mutagenesis (SLIM): A Single-Tube Methodology Approaching 100% Efficiency in 4 H. Nucleic Acids Res. 2004, 32, e174. [Google Scholar] [CrossRef]
- A Fyfe, J.; Harris, G.; Govan, J.R. Revised Pyocin Typing Method For Pseudomonas Aeruginosa. J. Clin. Microbiol. 1984, 20, 47–50. [Google Scholar] [CrossRef]
- Sambrook, J.; Fritsch, E.F.; Maniatis, T. Molecular Cloning: A Laboratory Manual; Cold Spring Harbor Laboratory Press: Cold Spring Harbor, NY, USA, 1989. [Google Scholar]

| Strains | Products |
|---|---|
| TT6-1 | ATPase associated with various cellular activities, AAA_5, MoxR-like ATPase |
| TT6-2 | bacteriophage tail protein [Escherichia coli E22] |
| TT6-3 | peptidase S8 and S53 subtilisin kexin sedolisin; killer protein of pyocin S3 |
| TT6-4 | bacteriophage tail protein [Escherichia coli E22] |
| TT6-5 | putative periplasmic ligand-binding sensor protein |
| TT6-6 | diguanylate cyclase AdrA [Shigella boydii Sb227] |
| TT6-9 | bacteriophage tail protein [Escherichia coli E22] |
| TT6-10 | putative phage tail fiber protein [Escherichia coli E24377A] |
| TT6-13 | killer protein of pyocin S3 |
| TT6-14 | putative bacteriophage protein GP48 |
| TT6-19 | putative phage tail fiber protein [Escherichia coli E24377A] |
| TT6-21 | killer protein of pyocin S3 |
| TT6-22 | bacteriophage tail protein [Escherichia coli E22] |
| Strain or Plasmid | Relevant Characteristics | Source of Reference |
|---|---|---|
| Escherichia coli | ||
| DH5α | SupE44 ΔlacU169 (Φ80 lacZ ΔM15) hsdR17 recA1 endA1 gyrA96 thi-l relA1 | Hanahan; Reusch et al. [33,36] |
| 1803 | pro−met−KmrNmr, containing transposon Tn5 on the suicidal plasmid pBJ4JI | Gantotti et al. [37] |
| Pectobacterium carotovorum subsp. carotovorum | ||
| TO6 | Pcc, Ampr, wild type, putative biocontrol agent | Laboratory stock |
| Rif-TO6 | Pcc, Ampr, Rifr, wild type | Laboratory stock |
| 89-H-4 | Pcc, Ampr, wild-type, putative biocontrol agent | Laboratory stock |
| 89-H-rif-12 | Pcc, Ampr, Rifr, wild type | Laboratory stock |
| 3F3 | Pcc, Ampr, wild type | Laboratory stock |
| SP33 | Pcc, wild-type indicator strain | Laboratory stock |
| H-rif-89-12/∆dgc-Kan | Pcc, Ampr, Rifr, Kanr, wild type | This study |
| H-rif-89-12/∆dgc-Tet | Pcc, Ampr, Rifr, Tetr, wild type | This study |
| Plasmids | ||
| pJB4JI | suicide vector for Tn5, pJB4JI, contains pPH1JI, bacteriophage Mu, and Tn5 | P.R. Hirsch, J.E. Beringer, [38] |
| pGEM T-Easy | Ampr, lacZ cloning vector | Promega |
| pBR322 | Ampr, Tetr | Bolivar et al. [21] |
| pG-dgc | pGEM T-Easy, Ampr, dgc | This study |
| pG-dgc-Xho1/Hpa1 | pGEM T-Easy, Ampr, dgc | This study |
| pG-Tet | pGEM T-Easy, Ampr, Tetr | Laboratory stock |
| pG-Δdgc-T | pGEM T-Easy, Ampr, dgc, Tetr | This study |
| pG-Δdgc-K | pGEM T-Easy, Ampr, dgc, Kanr | This study |
| Primers | Sequence (5′-3′) |
|---|---|
| P3 | CTCGACGTTGTCACTGAAGCGGGAAG |
| P4 | AAAGCACGAGGA GCGGTCAGCCCAT |
| PF1 | AGAGA ACACAGATTTAGCCCAGTCGG |
| PF2 | CCGCACGATGAAGAGCAGAAGTTAT |
| PF3 | GATCCTGGAAAACGGGAAAGGTTC |
| PR1 | GCCGAAGAGAACACAGATTTAGCCCA |
| PR2 | CCGCACGATGAAGAGCAGAAGTT |
| Pcc_DGC_F_upstream | CTCACTGTTGCTGACATGC |
| Pcc_DGC_R_downstream | ATTCAGGCAACTTCGGTTC |
| DGC_Xho1_Fs | CGACAATCCGTGGAATATAG |
| DGC_Xho1_Ft | CTCGAGCGACAATCCGTG |
| DGC_Xho1_Rs | GTACGATACTGTGCGCTC |
| DGC_Xho1_Rt | CTCGAGGTACGATACTGTG |
| DGC_Hpa1_Fs | GATAAGCTCTCCCGAATACG |
| DGC_Hpa1_Ft | GTTAACGATAAGCTCTCCCG |
| DGC_Hpa1_Rs | GCTGAAGTTTCTGAACCAG |
| DGC_Hpa1_Rt | GTTAACGCTGAAGTTTCTGAAC |
| F-16s- sense-ECC | CTGGACAAAGACTGACGCTC |
| R-16s- sense-ECC | TCGCTGGCAACAAAGGATAAG |
| caroS2K_RT_F | GAGATACAATGACCGTGGATGG |
| caroS2K_RT_R | GCAACTGGTGTTACCGTAACTG |
| caroS3K_RT_F | ATGATTAAGTACCGTTTATATGCTC |
| caroS3K_RT_R | TCATTGCGACTCCCTCATAT |
| CaroS4KI_RT_R | GGATCCATGATTAATTTTAAGG |
| CaroS4KI_RT_R | GAGCTCTTAGAGACCGTAT |
| CRP_RT_F | CTCTCGAATGGTTCCTTTCC |
| CRP_RT_R | GAGATCAGGTTCTGGTCTTC |
| FlhA_RT_F | TCACTCAAGCTTGCATCTAC |
| FlhA_RT_R | AAGCTTTCACTTCTGAGCTTCC |
| GlnH_ RT_F | ACAGACCGGTGAATTACGCATCGG |
| GlnH_ RT_R | GCCGCTACGCCTTCATCCATATTC |
| FliG sense | ATGACCCTGACAGGAACAG |
| FliG antisense | TTAGACATAAGCATCCTCGC |
| DY-F1 | GGTAGGATCCGTTGTTAGGTGCATAGGTTGG |
| DY-R1 | TTCAAGCTTGTGGTGAATTGACAATACGC |
Publisher’s Note: MDPI stays neutral with regard to jurisdictional claims in published maps and institutional affiliations. |
© 2022 by the authors. Licensee MDPI, Basel, Switzerland. This article is an open access article distributed under the terms and conditions of the Creative Commons Attribution (CC BY) license (https://creativecommons.org/licenses/by/4.0/).
Share and Cite
Lagitnay, R.B.J.S.; Chen, H.-L.; Chen, Y.-C.; Chuang, D.-Y. Diguanylate Cyclase (DGC) Implicated in the Synthesis of Multiple Bacteriocins via the Flagellar-Type III Secretion System Produced by Pectobacterium carotovorum subsp. carotovorum. Int. J. Mol. Sci. 2022, 23, 5649. https://doi.org/10.3390/ijms23105649
Lagitnay RBJS, Chen H-L, Chen Y-C, Chuang D-Y. Diguanylate Cyclase (DGC) Implicated in the Synthesis of Multiple Bacteriocins via the Flagellar-Type III Secretion System Produced by Pectobacterium carotovorum subsp. carotovorum. International Journal of Molecular Sciences. 2022; 23(10):5649. https://doi.org/10.3390/ijms23105649
Chicago/Turabian StyleLagitnay, Ruchi Briam James Sersenia, Han-Ling Chen, Yen-Chun Chen, and Duen-Yau Chuang. 2022. "Diguanylate Cyclase (DGC) Implicated in the Synthesis of Multiple Bacteriocins via the Flagellar-Type III Secretion System Produced by Pectobacterium carotovorum subsp. carotovorum" International Journal of Molecular Sciences 23, no. 10: 5649. https://doi.org/10.3390/ijms23105649
APA StyleLagitnay, R. B. J. S., Chen, H.-L., Chen, Y.-C., & Chuang, D.-Y. (2022). Diguanylate Cyclase (DGC) Implicated in the Synthesis of Multiple Bacteriocins via the Flagellar-Type III Secretion System Produced by Pectobacterium carotovorum subsp. carotovorum. International Journal of Molecular Sciences, 23(10), 5649. https://doi.org/10.3390/ijms23105649








